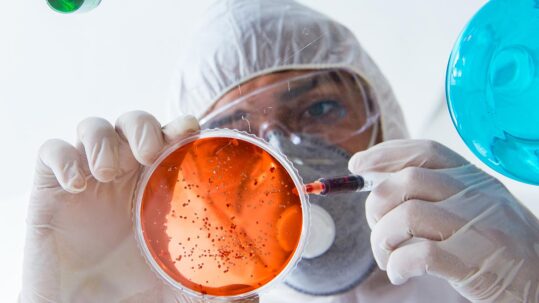
m

Orari
Lunedi
07:00 - 20:00
Martedì
07:00 - 20:00
Mercoledì
07:00 - 20:00
Giovedì
07:00 - 20:00
Venerdì
07:00 - 20:00
Sabato
07:00 - 20:00
Domenica
07:00 - 20:00
Servizi
A domicilio
A domicilio
Sanitary Safety porta l’assistenza direttamente alla porta di casa tua. Con operatori qualificati e un approccio centrato sul paziente, garantiamo una cura confortevole e su misura nel comfort del tuo ambiente domestico.
Strutture specializzate
Strutture specializzate
Collaboriamo con strutture specializzzate per offrire soluzioni socio-sanitarie avanzate.Ci impegniamo a garantire un ambiente di cura ottimale all’interno di strutture mediche, per il benessere completo dei pazienti.
Poliambulatori
Poliambulatori
Selezioniamo professionisti qualificati per qualsiasi vostra esigenza, troviamo le soluzioni adatte alle vostre esigenze, gestendo direttamente il servizio.
Medicina del Lavoro
Medicina del Lavoro
Sanitary Safety si impegna a fornire non solo consulenze mediche, ma anche programmi di terapie personalizzati e supporto psicologico dedicato. Garantiamo un’esperienza di cura completa e accessibile ovunque tu sia.

Strutture specializzate

A domicilio

Poliambulatori

Medicina del Lavoro
Servizi
Infermieri
Persone assistite
Anni di esperienza
Matching Sanitary Safety
In Sanitary Safety, ci impegniamo a rendere il processo di ricerca di assistenza socio sanitaria più efficiente e personalizzato che mai. Con il nostro approccio “Matching Sanitary Safety,” garantiamo una perfetta sintonia tra le tue esigenze e l’operatore socio sanitario ideale.
Come Funziona il Matching Sanitary Safety:
Compila il form: Compila il nostro form online dettagliato, fornendo le informazioni necessarie per capire appieno le tue esigenze.
Seleziona il Servizio: Scegli tra una vasta gamma di servizi socio sanitari, per aiutarci a comprendere l’area di intervento.
Troviamo l’Operatore Adatto: Utilizzando il matching Sanitary Safety, identifichiamo l’operatore socio sanitario perfetto per te tra i nostri professionisti altamente qualificati.
Ricevi la Soluzione via mail: Riceverai rapidamente una proposta personalizzata, garantendo che tu possa accedere al supporto di cui hai bisogno in tempi brevi.
Ultime News
-
-
Salute per tutti tramite la Primary Health Care
13 Dicembre, 2023 -
Vantaggi della Vaccinazione Antinfluenzale negli Anziani
13 Dicembre, 2023